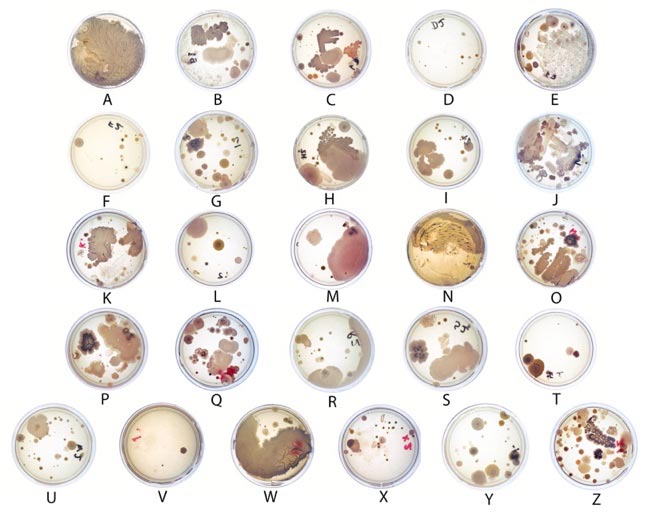
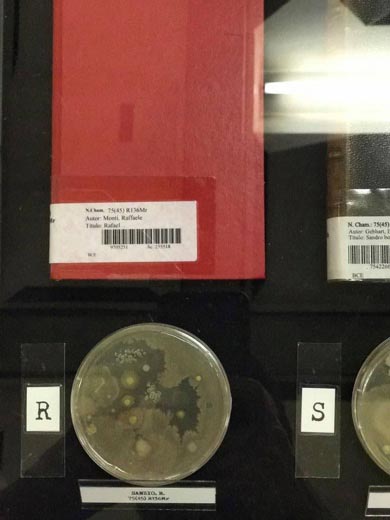

O texto na versão original pode ser encontrado em: https://zenodo.org/records/10413741
(GT 7 – Narrativas ecotecnológicas dos corpos)
Bioarte: correlações e desafios na produção com seres vivos
Dr. Breno Tenório Ramalho de Abreu (UnB e UFG)
Dra. Thatiane Mendes Duque (UEMG)
Graduado Igor Reis (UEMG)
RESUMO
A abertura do campo da arte, no último século, para novos modos de fazer e pensar o objeto de arte, implica na necessidade de refletirmos mais sobre as materialidades existentes e seus usos. É cada vez mais frequente observar artistas que incorporam seres vivos na produção de seus trabalhos, muitas vezes de maneira colaborativa. Este artigo apresenta correlações entre a produção de três artistas contemporâneos que tem interagido com culturas de seres vivos: abelhas, plantas, bactérias e fungos. Assim, como estudo de caso analisaremos as obras: Abcedário (2017) de Breno Abreu; Habitáveis (2018-2023) de Igor Reis; e Tecidos fúngicos de família (2021) de Thatiane Mendes. Estes trabalhos apontam para várias especificidades e desafios presentes neste tipo de produção em Bioarte que necessitam serem identificadas e investigadas.
Palavras-chave: Bioarte; materialidade; seres vivos; arte contemporânea.
ABSTRACT
The opening of the field of art, in the last century, to new ways of making and thinking about the object of art, implies the need to reflect more on the existing materialities and their uses. It is increasingly common to observe artists who incorporate living beings in the production of their work, often in a collaborative way. This article presents correlations between the production of three contemporary artists who have interacted with cultures of living beings: bees, plants, bacteria and fungi. Thus, as an example, we will analyze the works: Abcedário (2017) by Breno Abreu; Habitable (2018-2023) by Igor Reis; and Family fungal textiles (2021) by Thatiane Mendes. These works point to several specificities and challenges present in this type of production in Bioart that need to be identified and investigated.
Keywords: Bioart; materiality; living beings; contemporary art.
INTRODUÇÃO
A bioarte tem sido uma das primeiras vanguardas artísticas do século XXI a se destacar, transformando os formatos e conceitos de apresentação tradicional das artes, utilizando para isso materiais orgânicos, geralmente um organismo vivo ou produtos criados a partir deles, como ferramenta artística, envolvendo plantas, insetos, microrganismos, placas de Petri, tubos de ensaio, dentre outros (MEDINA, 2007, pg. 2).
Muitos desses trabalhos envolvem coletivos formados por especialistas de diferentes áreas como arte, design, biologia, química e engenharia, de maneira interdisciplinar e colaborativa, pois acabam necessitando de muitos conhecimentos técnicos e artísticos que dificilmente seriam conduzidos unilateralmente.
Nesse sentido, o objetivo deste artigo é investigar e identificar as especificidades e desafios na produção de bioarte utilizando seres vivos por meio da comparação entre 3 obras de arte: Abcedário (2017) de Breno Abreu, Habitáveis (2018-2023) de Igor Reis e Tecidos fúngicos de família (2021) de Thatiane Mendes.
Reconhecer essas especificidades e desafios pode ser uma fonte de informação para quem pretende desenvolver obras e artefatos utilizando microrganismos e outros seres viventes como plantas e animais, que vai além de questões de cunho prático e técnico no desenvolvimento das mesmas, mas também implicações de segurança e ética.
O artigo então usa como método o estudo de caso das obras a serem descritas e discutidas em subcapítulos a seguir e posteriormente as considerações finais, onde as obras serão comparadas para elencar os desafios enfrentados em suas produções, exposições e conservações.
1 – HABITÁVEIS (2018-2023) DE IGOR REIS
As materialidades presentes no mundo têm tido um papel fundamental na construção do objeto de arte, sobretudo na escultura contemporânea. Desta maneira, cada objeto ou material utilizado expressa um conjunto de significados estabelecidos dentro dos contextos sociais aos quais estes elementos pertencem. Evocar as simbologias destas materialidades através de sua aglutinação tem sido uma prática comum na construção de sentidos e significados no campo das artes. Contudo, existem matérias vivas, complexas e com inteligências próprias que atuam no mundo e desenvolvem seus papéis nos ecossistemas aos quais estão inseridas.
Trabalhar com materialidades vivas na arte desconstrói a ideia de que a arte é meramente uma representação ou interpretação simbólica do mundo. Ao invés disso, a incorporação de elementos vivos na criação artística permite uma experiência direta e imersiva com a vida em si. No intuito de investigar essas relações analisaremos a pesquisa da série Habitáveis, de Igor Reis.
Habitáveis é uma pesquisa que envolve a produção de esculturas cerâmicas desenvolvidas com o intuito de estabelecer relações dialógicas e colaborativas entre seres vivos, no caso abelhas. A participação das abelhas nativas no processo de desenvolvimento de esculturas cerâmicas destaca a necessidade de coexistência e de respeito a presença de outros entes vivos. As abelhas, como polinizadoras essenciais, são fundamentais para a reprodução de plantas e para a manutenção dos ecossistemas, mas nos últimos anos tem sofrido com políticas de impacto ambiental e perda de habitat. Ao reconhecer sua importância e incluí-las no processo artístico, a pesquisa nos convida a repensar nosso estilo de vida e a encontrar maneiras de estabelecer relações harmônicas entre as áreas de conhecimento que atuamos e os biomas. Corroborando com as ideias do geografo e escritor Milton Santos, que enfatiza: “Desfetichizar o homem e o espaço é arrancar à Natureza os símbolos que ocultam a sua verdade” (SANTOS, 1982, p. 25).
Foi nos últimos seis anos morando em zona rural de Brumadinho, parte deles no bioma de transição entre Mata Atlântica e Cerrado que o artista desenvolveu as primeiras esculturas cerâmicas para serem ocupadas por abelhas. A princípio, não houve interações significativas entre as abelhas nativas, mas após seis meses da primeira inserção em meio ambiente, as abelhas começaram a ocupar pouco a pouco cada trabalho. As abelhas chamadas de “campeiras” visitam as esculturas e começam a preparar o ambiente interno da escultura. O volume de abelhas se intensifica ao longo dos dias e cerca de uma semana depois se observa centenas de indivíduos entrando na escultura (figura 3).
Figura 3. Simbiose #9, Cerâmica 1280 ºC, 40 x 24 x 18 cm, 2023 (esquerda). Habitáveis #1, Cerâmica, 45 x 30 x 30 cm, 2018 (direita).
Fonte: autoria própria.
As abelhas nativas, também chamadas de abelhas sem ferrão pertencem à família Apidae, tribo Meliponini, razão pela qual são chamadas de meliponíneos. De acordo com a Revista Embrapa são 52 gêneros e mais de 300 espécies identificadas com distribuição registrada para a maioria dos países do hemisfério sul presentes em todo o território. A escolha por abelhas nativas se sucedeu, segundo o autor, primeiramente por conexões afetivas e pelo desejo de aproximação. Toda via, se tratando de seres vivos, foi necessário observar seu comportamento, compreender suas necessidades, origem e locais de ocorrência das espécies. Com o propósito de aprendizado, consultou criadores de abelhas, aprendeu e aplicou técnicas de manejo, frequentou cursos de meliponicultura urbana. Porém, a divergência com os métodos de manejo de exploração de meliponicultores, o levou a se distanciar e continuar a pesquisa de maneira empírica.
As esculturas são produzidas ocas em argila e após a queima em baixa ou alta temperatura, 1050ºC ou 1280ºC, são instaladas em espaços urbanos, rurais ou matas nativas. Após sua instalação, passam a ser visitadas por abelhas da região. As abelhas visitam as esculturas, e quando se interessam passam a frequentar a escultura até que por fim, nidificam formando colônia em seu interior. Do verbo habitar, Habitáveis significa: que pode ser habitado, ou seja, habitar as esculturas é um fenômeno que pode ou não acontecer e isso depende da liberdade de escolha das abelhas. Desta maneira, à medida que o desenvolvimento das esculturas aconteceu, os processos de manejo foram sendo retirados. Atualmente a pesquisa não utiliza manejo ou manuseio. As abelhas escolhem as esculturas caso se interessem. É possível que as abelhas permaneçam por muitas décadas vivas, pois ao contrário da madeira, a cerâmica permanece resistente às intempéries. Em 6 anos de pesquisa, aproximadamente 12 esculturas foram ocupadas.
Por questões éticas e complexas que envolvem o processo de reprodução das espécies em ambiente natural, Igor Reis optou por não comercializar esculturas ocupadas por abelhas. Após a visitação, e interesse das abelhas em determinadas esculturas, as esculturas permanecem nos locais de maneira permanente (figura 4). Desta maneira, a forma de circulação desta proposição artística se dá de maneira a respeitar a especificidade de localização das espécies. A comercialização das esculturas acontece sem a presença de abelhas em seu interior.
A especificidade de localização é uma problemática a esta proposição que dificulta a circulação da proposta no circuito formal do sistema da arte, como galerias, mas que funciona melhor em programas que envolvam intervenções em ambientes externos ou residências artísticas.
Habitáveis é uma proposição que se encaixa em muitas definições dentro do campo da arte, e se associam as paisagens rurais e urbanas. São construídas dentro de uma lógica escultural e como pequenas arquiteturas para não humanos, se instalam em ambientes externos e atuam através das abelhas em um raio de mais 500 metros da escultura dependendo da espécie de abelha.
Figura 4. Habitáveis #5, cerâmica 1280º C, 65 x 25 cm, 2020 – 2021.
Fonte: autoria própria.
Consequentemente, as fronteiras que delineiam este tipo de produção são tênues como ressalta Rosalind Krauss (1984) ao se referir as esculturas do final dos anos 1960 especificamente a Land Art e Site specifc, definindo como campo ampliado as novas espacialidades escultóricas utilizadas na produção de Arte. O rompimento com a estrutura de pensamento modernista é substituído por lógicas que utilizam e manipulam meios incluindo sua associação com a paisagem e a arquitetura. Desta maneira, é importante destacar que a associação entre diversas matérias não deve se limitar ao rompimento com as matérias predefinidas do passado, mas repensar modos de fazer arte ampliando as possibilidades de interações e diálogos entre materialidades e organismos.
2 – ABCEDÁRIO (2017) DE BRENO ABREU
A obra Abecedário (2017) de Breno Abreu surgiu a partir de uma residência artística realizada durante o Doutorado em Artes da Universidade de Brasília (UnB) que tinha como objetivo que cada discente fizesse uma cartografia pessoal na biblioteca central da UnB e a partir daí e de suas experiências prévias desenvolvessem uma obra.
A escolha da biblioteca central para realizar a residência se deu com o objetivo de repensar esse espaço, que para muitos se tornou obsoleto desde o advento das mídias digitais e pesquisas on-line, e assim compreendê-la melhor e estabelecer relações entre o lugar físico, os livros e a palavra escrita, criando outras conexões e significados.
Previamente a realização da cartografia, foi realizado uma pesquisa bibliográfica para embasar a residência e o que poderia ser encontrado e discutido no espaço da biblioteca. Um dos principais autores utilizado foi Flusser em seu livro “A Escrita” (2010), no qual o autor se utiliza de uma metaescrita, para abordar desde a letra e o sinal gráfico até o livro. Uma das principais influências de Flusser neste trabalho vem da relação entre ciência e arte na escrita, onde para o autor a ciência pode se mostrar como forma artística e a arte como forma de conhecimento científico: “Não somos acostumados a adotar critérios estéticos para textos científicos, embora um tipo de crítica como essa fosse produtiva também para a ciência em termos de teoria do conhecimento” (FLUSSER, 2010, pg.39).
Após a pesquisa bibliográfica iniciou-se a vivência na biblioteca. Primeiramente foi criado uma espécie de planta baixa (mapa) da biblioteca para entender sua divisão e o que poderia ser encontrado em cada ambiente. Nesse desenho inicial percebeu-se que a biblioteca de fato é um local do conhecimento, do silêncio, das reflexões, quase como um local sagrado, onde se buscam respostas, ou na verdade se encontram respostas para se elaborar novas perguntas.
“Assim como outros símbolos culturais, os mapas podem ser interpretados como uma forma de discurso, constituídos por um sistema de signos cujos códigos podem ser icônicos linguísticos ou numéricos” (CADÔR, 2016, pg. 492). Nesse caso, o mapa realizado na biblioteca central mostra o espaço em um determinado período de tempo, mas que é permeado por muitas simbologias. Um fator que se destacou nesse mapeamento foi a presença da poeira nos livros, que indicam a passagem do tempo.
Além disso, a poeira nos faz pensar sobre a vida de cada um daqueles livros. Onde foram publicados? De onde vieram? Em quais mãos e casas passaram? Talvez a poeira presente em cada um deles simbolize as suas histórias, e em cada partícula de poeira temos diversos microrganismos como bactérias e fungos, que podem recontar a história de por onde estiveram, um elo de ligação entre microbiologia e a biblioteca.
A partir deste momento procurou-se por mais conexões entre microrganismos, arte e biblioteca nos livros da seção de referências. A única relação estabelecida foi por meio do significado da palavra biblioteca que poderia ser tanto do grego, caixa de livros, quanto significar biblioteca gênica, onde por meio de cortes no DNA podemos fazer a leitura do material gênico.
Dessa maneira, resolveu-se criar uma ligação entre arte e microrganismos, organizados em uma espécie de biblioteca. Assim, criou-se uma pequena biblioteca com livros que versassem sobre artistas com nomes próprios de A a Z, nos quais foram coletados a poeira de dentro e da lombada, e colocados para crescer em um meio de cultura não específico, próprio para o crescimento de fungos e bactérias desconhecidas, tornando-as assim visíveis a comunidade.
A coleta dos microrganismos presentes na poeira foi realizada na biblioteca central por meio de uma performance, onde foram separados os 26 exemplares de livros com seus respectivos números de chamada como consta na figura 1. Os microrganismos foram coletados com o auxílio de um cotonete estéril em solução salina e colocados para crescer em meio Ágar Mueller Hinton (peptona de caseína 17,5 g/L, peptona de carne 2,0 g/L, amido 1,5 g/L, ágar 17,0 g/L, água destilada q.s.p., pH final 7,3) em estufa à 37 °C por 48 horas. Depois de crescidas as placas (figura 1) passaram por um processo de preservação utilizando parafina gel, para que durassem mais tempo e não entrassem em contato com o público visitante da exposição.
O material foi exposto na biblioteca central da UnB em mesas protegidas por vidro onde estavam visíveis os livros, a letra referente a primeira letra do nome do artista do qual se trata o livro, o código de cadastro do livro na biblioteca e a placa com o que havia crescido de microrganismos coletados naquele livro, conforme figura 2.
Figura 1. Placas com microrganismos originários de livros da biblioteca que versam sobre artistas de A à Z.
Fonte: autoria própria.
Figura 2. Livro exposto com sua respectiva colônia de microrganismos crescidos (esquerda); expositor com os livros e placas contendo microrganismos de A à G (direita).
Fonte: autoria própria.
No dia em que a obra foi exposta na Biblioteca Central da UnB, acabou causando um grande alarde na comunidade, talvez por materializar aquilo que antes era invisível, os microrganismos, o que gerou uma descoberta e ao mesmo tempo um desgosto nos usuários. No mesmo dia a própria biblioteca recolheu a obra alegando que a mesma poderia causar uma má impressão da biblioteca central e de sua política de higienização periódica.
O trabalho desenvolvido entre arte, ciência e a biblioteca aponta para a esfera do conhecimento do invisível, o que está nas entrelinhas e que talvez seja a resposta para muitos problemas. As obras apresentadas podem conter outros conhecimentos ainda desconhecidos, por estarem escritas em linguagens além da linguagem escrita, como a linguagem gênica.
Partimos assim de macro bibliotecas de livros, para pequenas bibliotecas de palavras (livros) para chegar a microscópicas bibliotecas gênicas, repletas de conhecimento. Dessa maneira dilatamos a linguagem, criamos neologismos e que ampliam o entendimento que temos desse espaço chamado biblioteca.
3 – TECIDOS FÚNGICOS DE FAMÍLIA (2022) DE THATIANE MENDES
Sabe-se que um dos principais problemas da monocultura é que o cultivo de uma única espécie acaba causando um desequilíbrio no ecossistema, como nos diz Lins Margullis (2020), porque natureza é relação, é encontro entre espécies distintas.
Os fungos atuam como os “composteiros”, junto ao que costumamos relacionar com os restos, com o término de um ciclo. Nesta atuação, os fungos são capazes decompor diferentes resíduos agrícolas, podendo atuar junto com as plantas facilitando o acesso ao alimento para ela (como as micorrizas). Alguns fungos têm a capacidade de usar enzimas e ácidos que podem quebrar as substâncias mais difíceis do planeta: rochas, óleo cru, plástico e rejeitos de mineração.
Reconhecemos nestas ações, não o fim de ciclos, mas sim, de fenômenos como a associação, comunicação, colaboração entre espécies, porque a natureza nos mostra sempre que para sobreviver, além de adaptação, necessita-se de simbiose e colaboração. O fungo não faz com que a madeira da árvore deixe de existir, a madeira continua existindo, mas de uma outra maneira.
Para identificar estas relações, trazemos em modo de exemplificação, a série Tecidos fúngicos de família 2022: Família Ganoderma, Família Djamor, Família Trâmites e Família Citrinos de Thatiane Mendes. Segundo a artista pesquisadora, trata-se de cultivos entre têxteis afetivos e fungos. O intuito foi investigar como o micélio (célula dos fungos) pode ser combinado com bases têxteis, para desenvolver processos bio-integrados de fabricação de têxteis sustentáveis.
Assim a própria dinâmica de crescimento do micélio leva a artista a considerar diversos aspectos de beneficiamentos têxteis, como por exemplo: textura, estrutura e coloração. Neste processo de crescimento micelial as suas dinâmicas vivas são incorporadas, como práticas sustentáveis, aos tecidos. Em modo especulativo, Mendes acredita que estes processos dinâmicos e vivos podem no futuro substituir os processos tradicionais de beneficiamento têxtil.
Assim, em Tecidos fúngicos de família, foram investigadas como desenvolver ações colaborativas fúngicas: remendar, costurar, tecer, engomar, padronizar, plissar, revestir, criar tingir com o revestimento do micélio em parte do tecido, criar padrão (figura 5).
Figura 5. Tecidos fúngicos famíliae 1. Família Ganoderma 1. Thatiane Mendes, 2022
Fonte: autoria própria.
Nesta serie, foram cultivados tecidos junto com fungos para que eles possam desenvolver novas texturas sobre os tecidos nos quais estão situados/inoculados, e a partir do seu crescimento outras superfícies – redes são criadas. A proposta é verificar futuramente a possibilidade de criar vestíveis feitos de tecidos colonizados por fungos que podem atuar como rede sensorial distribuída. Segundo Merlin (2021), os fungos são conhecidos por responder a estímulos químicos e físicos que podem alterar sua atividade elétrica. Esse recurso permitiria a interface de vestíveis fúngicos com eletrônicos convencionais.
Diversos teóricos contemporâneos concordam que os fungos sentem luz, produtos químicos, gases, gravidade e campos elétricos. Além disso, segundo Merlin (2021), os fungos podem demonstrar respostas a mudanças no pH de um substrato, estimulação mecânica, metais tóxicos, CO2, hormônios do estresse. A estrutura criada pela conexão das hifas, formando essa rede de raízes chamada micélio, produz um tipo interconectividade radial. Por isso, os micélios têm sido cada vez mais investigados como um substrato formador de infraestruturas sustentáveis, que podem costurar e interligar partes que se encontram separadas. Deste modo, os fungos possuem um amplo potencial para estabelecer redes de tecidos inteligentes, que podem processar e interpretar os dados do ambiente e responder a estes estimulados.
Trata-se então de uma especulação: o que aconteceria se substituíssemos as máquinas de criar texturas têxteis por culturas de fungos sobre tecidos bases? Em um contexto de design de superfície, tais processos implicam em muitas questões como o tempo de produção, a durabilidade, ética, enfim, uma série de pontos que precisam ser investigadas para que um futuro têxtil mais sustentável e mais ecológico seja realidade.
CONSIDERAÇÕES FINAIS
As obras aqui apresentadas, abordam processos em arte e ciência, e deste modo acabam mesclando: investigações sensíveis pautadas por protocolos – procedimentos mais cuidadosos no envolvimento com seres vivos. Nas três obras citadas foram realizados estudos sobre o modo como estes seres convivem, como alimentam, quais as estruturas de suas “casas”, quais as temperaturas, para que não se altere o seu modo de vida e também para não modificar a genética desses seres.
Nas obras, Abcedário de Breno Abreu e Tecidos Fungicos Familie de Thatiane Mendes, podemos perceber como seres vivos microscópicos, não visíveis a olho nu, mas que como muito outros seres invisíveis para nossa perceção, tornam-se visíveis. Ao serem cultivados em placas de Petri, estes processos visibilizam a convivência com estes seres, que podem estar presentes em superfícies, dentro dos corpos, com suas diversas microbiotas intestinais e ao redor de outros, compondo a biodiversidade dos ecossistemas. Ignoramos a presenças destes pequenos seres, talvez por algo que está presente em nossa cultura: a germofobia, que é um termo criado por William Alexander Hammond (1879) referente a um medo patológico de entrar em contato com germes.
Portanto, as obras aqui apresentadas, sublinham formas distintas de convívio com estes pequenos seres. Os artistas preparam, os meios – lugares para que a vida ali aconteça, são processos que podem se modificar. Lugares onde abelhas podem se multiplicar, bactérias advindas de livros podem se tornar visíveis em placas de Petri, fungos juntos com tecidos podem conviver e formar novas tecituras.
REFERÊNCIAS
CADÔR, A. B. O livro de artista e a enciclopédia visual. Belo Horizonte: Editora UFMG, 2016.
FLUSSER, V. A escrita. Há futuro para a escrita? São Paulo: Annablume, 2010.
MERLIN, S. A trama da vida: como os fungos constroem o mundo. São Paulo: Editora Ubu, 2021.
REVISTA EMBRAPA. Criação de abelha-sem-ferrão. Disponível em: <https://ainfo.cnptia.embrapa.br/digital/bitstream/item/166288/1/CriacaoAbelhaSemFerrao.pdf>. Acesso em: <17/05/2023>.
SANTOS, M. Pensando o espaço do homem. Hucitec: São Paulo, 1982.